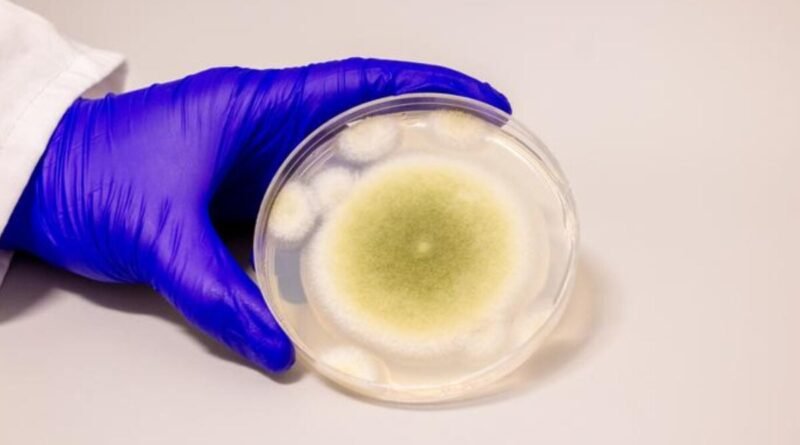

NASA’nın Yeni Nesil Roket Güçlendiricisi, Belki Hiç Uçmayacak Olan Tasarımının Testinde Patladı
NASA’nın Uzay Fırlatma Sistemi (SLS) roketinin geleceği belirsizliğini korurken, ajans, aracı Ay’a fırlatmak için gereken yeni bileşenlerin testlerine devam ediyor.